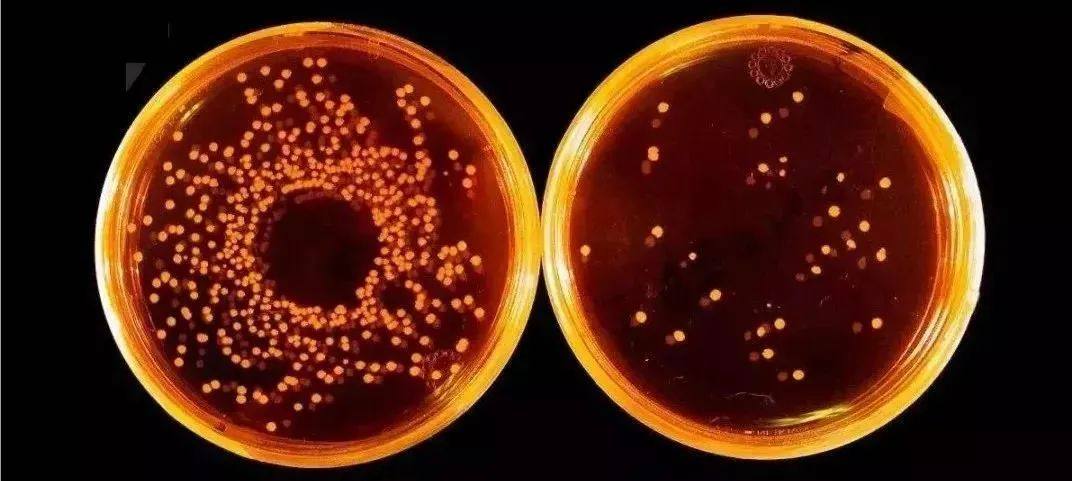
真的想不到,家里的洗衣机竟然是个病毒罐罐!一定要注意

家里的冰箱、洗衣机
空调、抽油烟机,
你有多久没有对他们做过清洁了?
他们后边所隐藏的细菌你看见了吗?[戴口罩]

小编很负责地告诉你,洗衣机的细菌病毒远比你想象中多!!
一到夏天,稍微一动弹就是一身汗,衣服湿透黏在身上不说,整个人还散发着一股子臭味。就算再怎么勤于换洗、爱干净的小编前段时间居然出了满身的红疹,抓啊挠啊久治不愈。

后来发现罪魁祸首竟然是——“洗衣机”!
每天洗衣服,我看到衣服洗得很干净,闻起来也很香,那自然也觉得洗衣机也是很干净的。但其实内壁日积月累的毛屑、污垢可真比粪池还要恶心!


有一次,我们的清洗师傅拆开了一位客户家里用了5年的洗衣机,家住成都武侯区的的赵女士都不敢想象,洗衣机的内桶可以脏到这种程度。用“比马桶还脏”来形容,也毫不夸张。想着一直用这样的内桶来清洗一家人的衣物,你慌了吗[泣不成声]......
成都周女士用了3年的内桶

长春周先生用了7年的内桶

长春刘先生用了13年的内桶

透过拿取衣物的机筒并不能看见污垢,但打开后的样子,有没有让你目瞪口呆!

上海疾病预防控制部门抽样调查显示:洗衣机细菌总数超标率为81.3%,总大肠菌群检出率为100%,霉菌率检出率为60.2%。半年没有清洗的洗衣机,细菌含量是马桶的530倍!细菌、病毒...从衣服袜子上掉落的微生物残留,滋生大量病菌、霉菌...

家里的老人、小孩、孕妇天天长时间有大面积皮肤接触那些病菌、霉菌、微生物,轻者瘙痒、过敏、出红疹,感染各种皮肤病,重者感染妇科疾病甚至有患癌风险。

部分图片来源于网络若侵 删
央视《是真的吗》栏目中医院皮肤科主任医师也曾明确指出,洗衣机内的污垢中的霉菌会引发皮肤性过敏,脚廯、手廯,霉菌性阴道炎、慢性*麻疹荨**等。

部分图片来源于网络,若侵 删
蚂蚁搬家
蚂蚁搬家,全国连锁品牌,1996年创立于成都,分公司遍布全国40余座城市,为数百万家庭和企事业单位提供专业的家庭服务。服务包括:搬家、货运、拆装、配送、家政、保洁、收纳、仓储等。同时,蚂蚁搬家全年不休24小时服务,随时可约,人车均为自营,安全可靠。收费透明,价格实惠。有品牌售后保障,搬家就选蚂蚁搬家,搬家拉货更轻松
所以定期清洁很有必要!常见清洗方式是自己动手清洗,清洁能力弱,杀菌抑菌能力也不足。还有一种方式就是请专业的家电清洗师傅上门,把里里外外拆装清洗,能把10年垃圾掏干净。用专业杀菌去毒的清洗工具,99%杀菌抑菌,除污防垢、祛除异味!预防皮肤病!

上周小编专门拿自家的洗衣机做了个实验,用我们清洗师傅提供的专业清洗剂,放进看起来很干净的洗衣机,却飘出了一堆脏东西!

经过洗涤-漂洗-脱水一系列程序后排出来的水真的脏得吓人!

污渍、脏东西全都出来了,洗衣机用3年了,心里总是犯膈应。前两天,洗了一件白色裤子,发现上面沾的都是脏东西,洗之前已经用清水洗了一下洗衣机,但还是没什么用,吓得我赶紧预约了师父上门清洗。

我朋友也说:“洗衣机用了好多年了,一直不知道它还需要清洗。”我也推荐她使用猫咪洗家电清洗服务。自己全程不需要动手,看着师傅洗出来好多脏东西,臭臭的,尤其是那个过滤网真的有点恶心。异味除去了,洗衣机一点没被损坏。“简直太棒了!以后必须每周清理一下!”


吴阿姨: 很多时候刚洗衣机捞出来衣服,上面就有灰色的污垢,一直以为是洗衣液清洁力度不够。直到有一次维修师傅拆开才看见里面暗藏的污垢,简直太触目惊心了。从那以后我基本上每隔段时间都要预约猫咪洗家电清洗服务。他们的服务真的很专业,清洗过后,洗衣机缝里、衣服上,再也没有任何脏东西了。

洗衣机长期接触细菌、污垢,加之长期处于潮湿的环境,极其容易繁衍细菌,并对人体造成二次伤害!

细菌繁殖发酵后产生一股臭味,衣服整日臭气熏天!再清香的洗衣液没有作用!感染皮肤病更是瘙痒难耐,洗衣机槽病菌侵袭已成为女性感染妇科病的“头号元凶”!只有找专业的清洗师傅、使用杀菌消毒的药水才能持续对抗有害细菌,如大肠杆菌,金黄色葡萄球菌,白色念珠菌一次清洗,除菌率高达99%!
孙女士:家里洗衣机用5年了,从来没清洗过。直到有一天发现刚洗好的衣服上有股子怪味,才联想到洗衣机的清洗问题。本来准备换一台,幸好老公在朋友圈看到我们有洗衣机清洗业务,就预约了。师傅清洗过后臭味儿也没了,洗衣机就跟新的一样。
(此处已添加小程序,请到*今条头日**客户端查看)
赶紧给家里的冰箱、洗衣机、抽油烟机来个大扫除吧!!